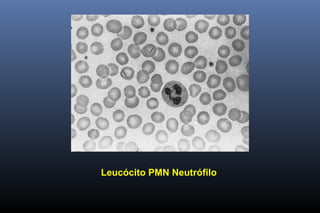
Leucócito PMN Neutrófilo

O documento descreve as principais células do sistema imune, incluindo linfócitos T e B, células apresentadoras de antígeno e leucócitos. Detalha os órgãos linfóides primários e secundários, como o baço e linfonodos, que hospedam as células imunes. Também define antígenos, imunógenos e epítopos, que são reconhecidos pelas células do sistema imune.